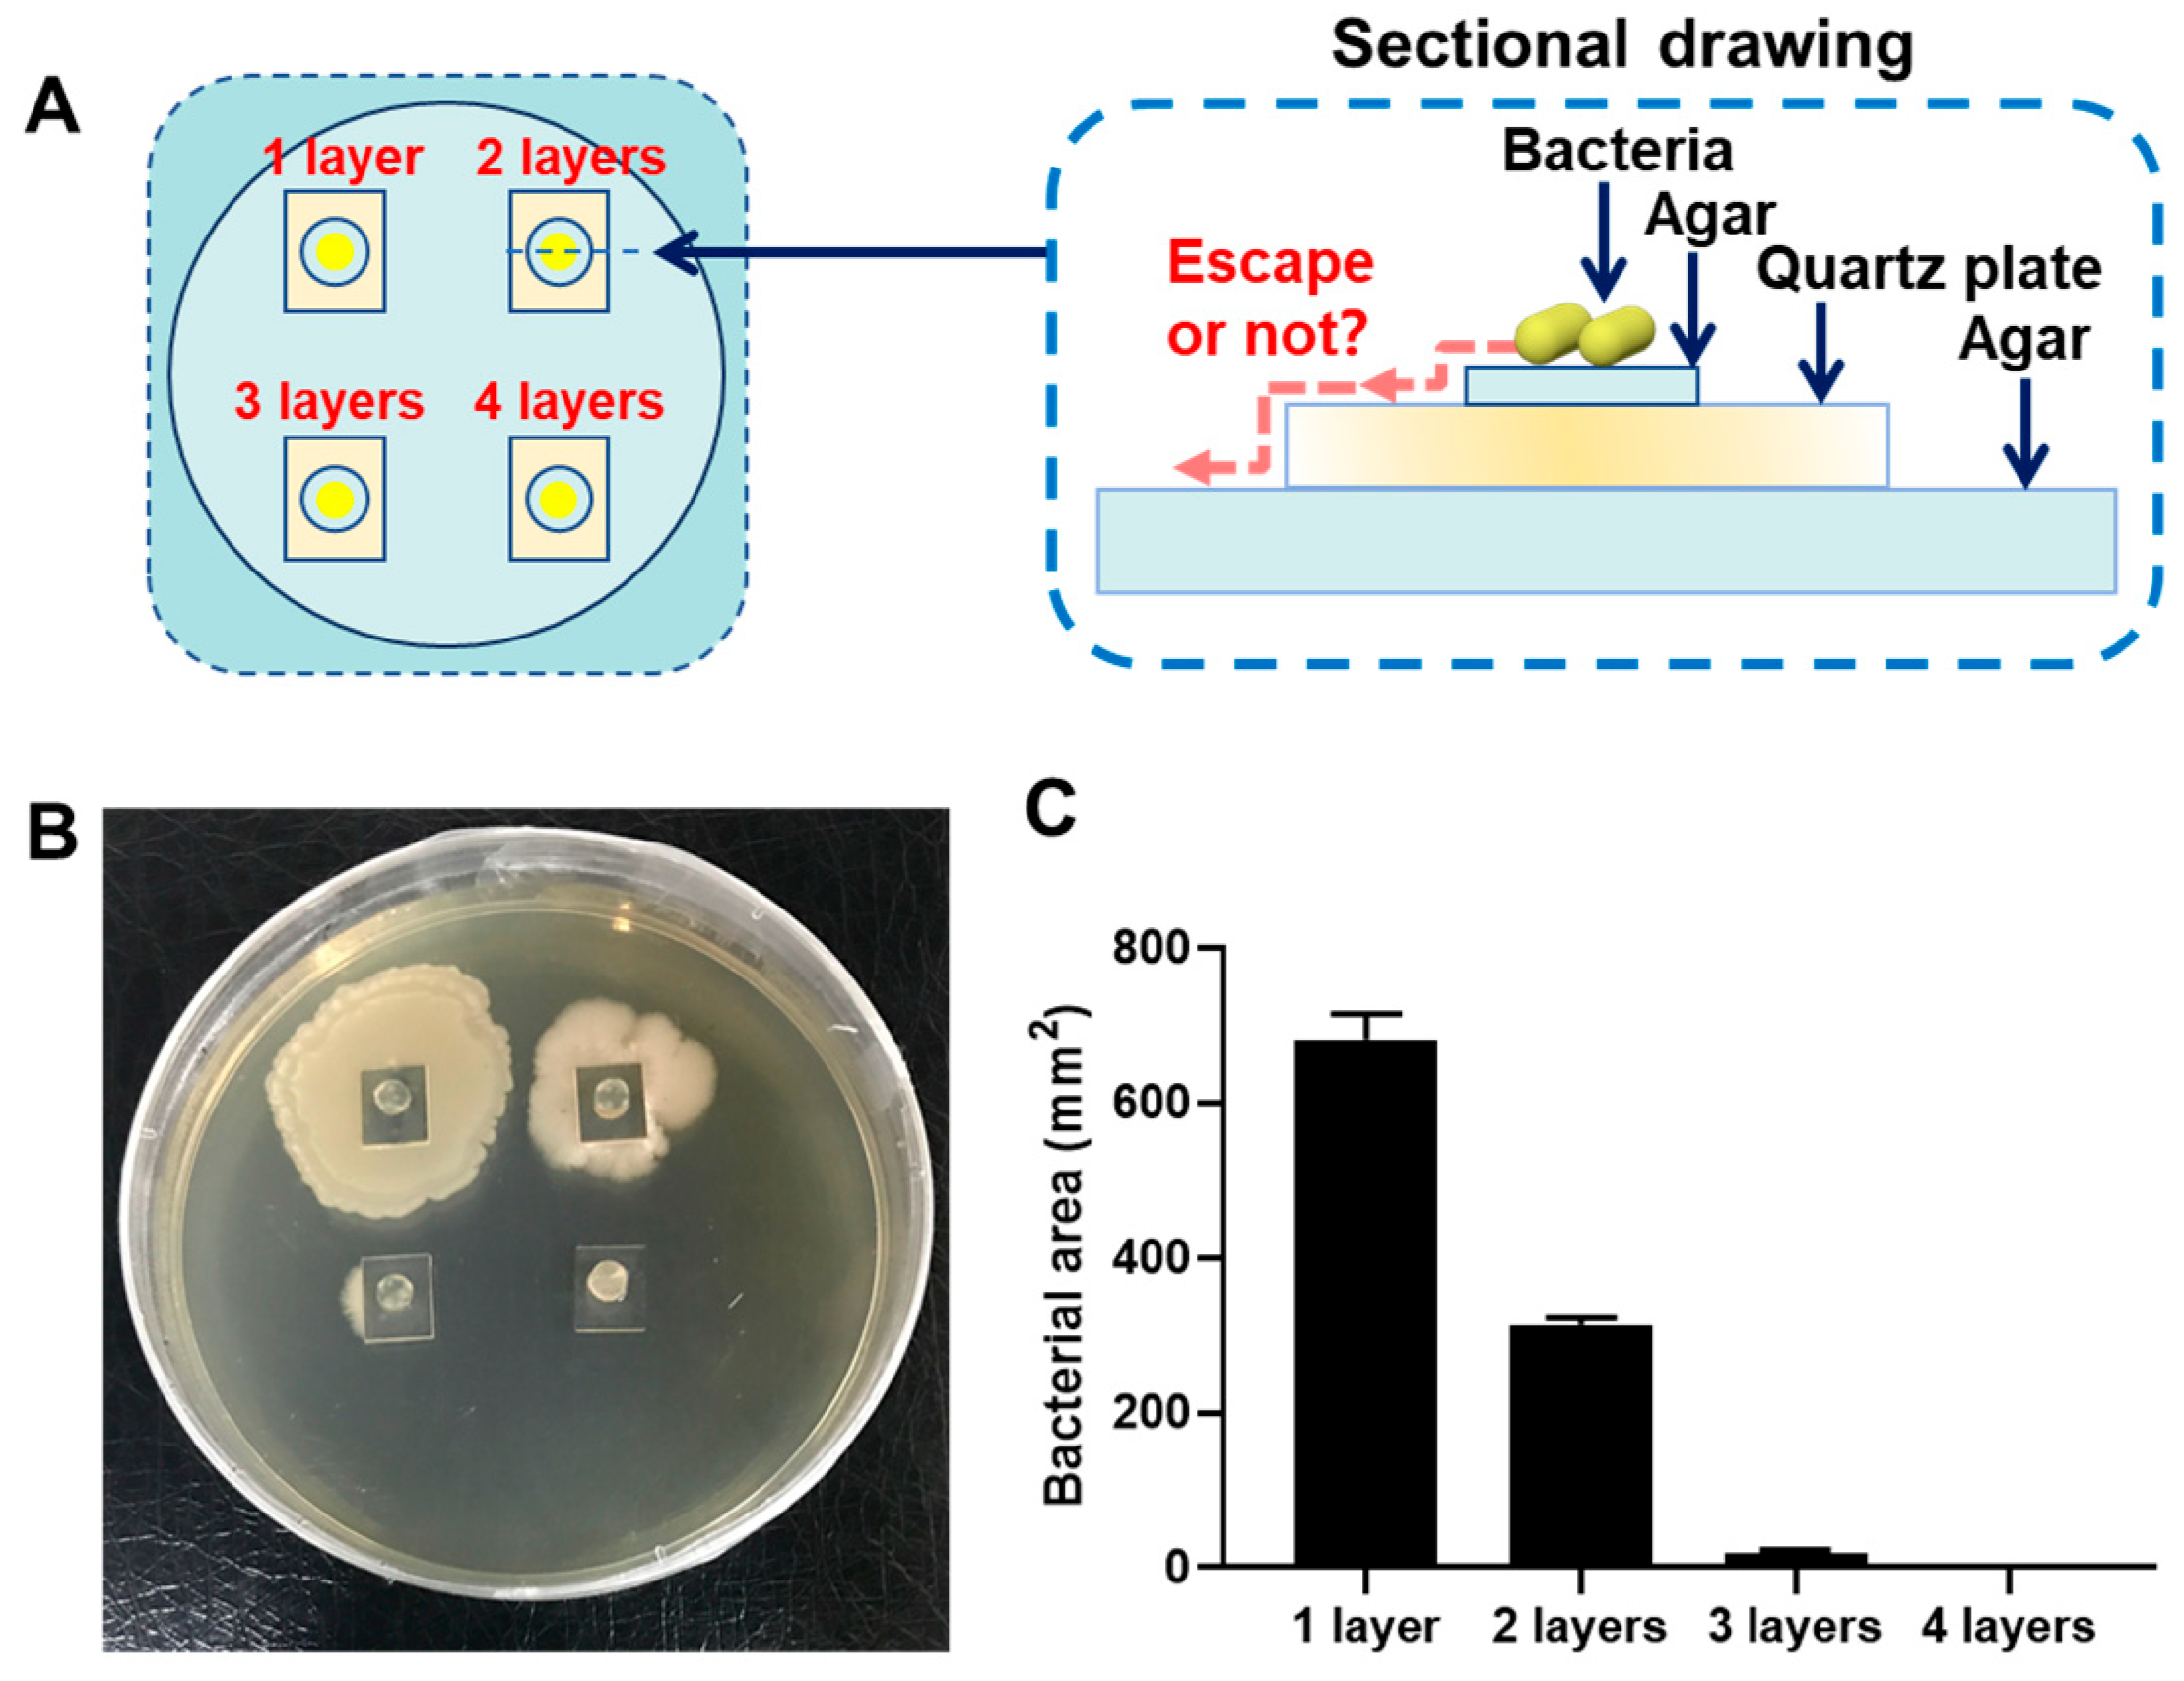
Coatings 14 00381 g002

Borneol-Modified Chitosan Coating with Antibacterial Properties via Layer-by-Layer Strategy
Abstract
1. Introduction
2. Materials and Methods
2.1. Materials
2.2. Preparation of BBr
2.3. Preparation of BP
2.4. Preparation of GCBP-Modified Quartz Plates
2.5. Construction of a GCBP-Modified Urinary Catheter Using LbL Method
2.6. Testing and Characterization
2.7. Antibacterial Assays
3. Results and Discussion
4. Conclusions
Supplementary Materials
Author Contributions
Funding
Institutional Review Board Statement
Informed Consent Statement
Data Availability Statement
Acknowledgments
Conflicts of Interest
References
- Li, J.; Wu, Y.; Zhao, L. Antibacterial activity and mechanism of chitosan with ultra high molecular weight. Carbohydr. Polym. 2016, 148, 200–205. [Google Scholar] [CrossRef] [PubMed]
- Sahu, A.; Goswami, P.; Bora, U. Microwave mediated rapid synthesis of chitosan. J. Mater. Sci. Mater. Med. 2009, 20, 171–175. [Google Scholar] [CrossRef] [PubMed]
- Di Nardo, T.; Hadad, C.; Nguyen Van Nhien, A.; Moores, A. Synthesis of high molecular weight chitosan from chitin by mechanochemistry and aging. Green Chem. 2019, 21, 3276–3285. [Google Scholar] [CrossRef]
- Yang, T.-C.; Li, C.-F.; Chou, C.-C. Cell age, suspending medium and metal ion influence the susceptibility of Escherichia coli O157: H7 to water-soluble maltose chitosan derivative. Int. J. Food Microbiol. 2007, 113, 258–262. [Google Scholar] [CrossRef] [PubMed]
- Li, J.; Zhuang, S. Antibacterial activity of chitosan and its derivatives and their interaction mechanism with bacteria: Current state and perspectives. Eur. Polym. J. 2020, 138, 109984. [Google Scholar] [CrossRef]
- Jeon, S.J.; Ma, Z.; Kang, M.; Galvão, K.N.; Jeong, K.C. Application of chitosan microparticles for treatment of metritis and in vivo evaluation of broad spectrum antimicrobial activity in cow uteri. Biomaterials 2016, 110, 71–80. [Google Scholar] [CrossRef]
- Su, Y.; Tian, L.; Yu, M.; Gao, Q.; Wang, D.; Xi, Y.; Yang, P.; Lei, B.; Ma, P.X.; Li, P. Cationic peptidopolysaccharides synthesized by ‘click’chemistry with enhanced broad-spectrum antimicrobial activities. Polym. Chem. 2017, 8, 3788–3800. [Google Scholar] [CrossRef]
- Verlee, A.; Mincke, S.; Stevens, C.V. Recent developments in antibacterial and antifungal chitosan and its derivatives. Carbohydr. Polym. 2017, 164, 268–283. [Google Scholar] [CrossRef]
- Jung, E.J.; Youn, D.K.; Lee, S.H.; No, H.K.; Ha, J.G.; Prinyawiwatkul, W. Antibacterial activity of chitosans with different degrees of deacetylation and viscosities. Int. J. Food Sci. Technol. 2010, 45, 676–682. [Google Scholar] [CrossRef]
- Chiu, H.-T.; Chen, R.-L.; Wu, P.-Y.; Chiang, T.-Y.; Chen, S.-C. A study on the effects of the degree of deacetylation of chitosan films on physical and antibacterial properties. Polym.-Plast. Technol. Eng. 2007, 46, 1121–1127. [Google Scholar] [CrossRef]
- Hamdine, M.; Heuzey, M.-C.; Bégin, A. Effect of organic and inorganic acids on concentrated chitosan solutions and gels. Int. J. Biol. Macromol. 2005, 37, 134–142. [Google Scholar] [CrossRef]
- Yang, R.; Li, H.; Huang, M.; Yang, H.; Li, A. A review on chitosan-based flocculants and their applications in water treatment. Water Res. 2016, 95, 59–89. [Google Scholar] [CrossRef]
- Zhao, X.; Wu, H.; Guo, B.; Dong, R.; Qiu, Y.; Ma, P.X. Antibacterial anti-oxidant electroactive injectable hydrogel as self-healing wound dressing with hemostasis and adhesiveness for cutaneous wound healing. Biomaterials 2017, 122, 34–47. [Google Scholar] [CrossRef]
- Foster, L.J.R.; Butt, J. Chitosan films are NOT antimicrobial. Biotechnol. Lett. 2011, 33, 417–421. [Google Scholar] [CrossRef]
- Zhang, D.; Zhang, X.; Sun, Q.; Zheng, S.; Hao, J.; Wang, Y. Continuous photocatalysis based on layer-by-layer assembly of separation-free tio2/reduced graphene oxide film catalysts with increased charge transfer and active site. Eur. J. Inorg. Chem. 2019, 5, 721–729. [Google Scholar] [CrossRef]
- Yan, Y.; Dong, S.; Jiang, H.; Hou, B.; Wang, Z.; Jin, C. Efficient and durable flame-retardant coatings on wood fabricated by chitosan, graphene oxide, and ammonium polyphosphate ternary complexes via a layer-by-layer self-assembly approach. ACS Omega 2022, 7, 29369–29379. [Google Scholar] [CrossRef] [PubMed]
- Decher, G. Fuzzy nanoassemblies: Toward layered polymeric multicomposites. Science 1997, 277, 1232–1237. [Google Scholar] [CrossRef]
- Phuvanartnuruks, V.; McCarthy, T.J. Stepwise polymer surface modification: Chemistry layer-by-layer deposition. Macromolecules 1998, 31, 1906–1914. [Google Scholar] [CrossRef]
- Dubas, S.T.; Schlenoff, J.B. Swelling and smoothing of polyelectrolyte multilayers by salt. Langmuir 2001, 17, 7725–7727. [Google Scholar] [CrossRef]
- Dai, J.; Bruening, M.L. Catalytic nanoparticles formed by reduction of metal ions in multilayered polyelectrolyte films. Nano Lett. 2002, 2, 497–501. [Google Scholar] [CrossRef]
- Zhao, Y.; Hu, J.; Hu, X.; Zhu, F.; Su, J.; Han, J. A novel strategy for fabrication of antistatic and antibacterial fabric via layer-by-layer self-assembly. Surf. Coat. Technol. 2023, 453, 129143. [Google Scholar] [CrossRef]
- Yi, H.; Wu, L.-Q.; Bentley, W.E.; Ghodssi, R.; Rubloff, G.W.; Culver, J.N.; Payne, G.F. Biofabrication with chitosan. Biomacromolecules 2005, 6, 2881–2894. [Google Scholar] [CrossRef]
- Luo, L.; Li, G.; Luan, D.; Yuan, Q.; Wei, Y.; Wang, X. Antibacterial adhesion of borneol-based polymer via surface chiral stereochemistry. ACS Appl. Mater. Interfaces 2014, 6, 19371–19377. [Google Scholar] [CrossRef]
- Hook, A.L.; Chang, C.-Y.; Yang, J.; Luckett, J.; Cockayne, A.; Atkinson, S.; Mei, Y.; Bayston, R.; Irvine, D.J.; Langer, R. Combinatorial discovery of polymers resistant to bacterial attachment. Nat. Biotechnol. 2012, 30, 868–875. [Google Scholar] [CrossRef]
- Yang, L.; Zhan, C.; Huang, X.; Hong, L.; Fang, L.; Wang, W.; Su, J. Durable antibacterial cotton fabrics based on natural borneol-derived anti-MRSA agents. Adv. Healthc. Mater. 2020, 9, 2000186. [Google Scholar] [CrossRef]
- Xin, Y.; Zhao, H.; Xu, J.; Xie, Z.; Li, G.; Gan, Z.; Wang, X. Borneol-modified chitosan: Antimicrobial adhesion properties and application in skin flora protection. Carbohydr. Polym. 2020, 228, 115378. [Google Scholar] [CrossRef]
- Shi, B.; Luan, D.; Wang, S.; Zhao, L.; Tao, L.; Yuan, Q.; Wang, X. Borneol-grafted cellulose for antifungal adhesion and fungal growth inhibition. RSC Adv. 2015, 5, 51947–51952. [Google Scholar] [CrossRef]
- Chen, C.; Xie, Z.; Zhang, P.; Liu, Y.; Wang, X. Cooperative enhancement of fungal repelling performance by surface photografting of stereochemical bi-molecules. Colloid Interface Sci. Commun. 2021, 40, 100336. [Google Scholar] [CrossRef]
- Sun, X.; Qian, Z.; Luo, L.; Yuan, Q.; Guo, X.; Tao, L.; Wei, Y.; Wang, X. Antibacterial adhesion of poly (methyl methacrylate) modified by borneol acrylate. ACS Appl. Mater. Interfaces 2016, 8, 28522–28528. [Google Scholar] [CrossRef] [PubMed]
- Cheng, Q.; Asha, A.B.; Liu, Y.; Peng, Y.-Y.; Diaz-Dussan, D.; Shi, Z.; Cui, Z.; Narain, R. Antifouling and antibacterial polymer-coated surfaces based on the combined effect of zwitterions and the natural borneol. ACS Appl. Mater. Interfaces 2021, 13, 9006–9014. [Google Scholar] [CrossRef] [PubMed]
- Zhang, P.; Chen, X.; Bu, F.; Chen, C.; Huang, L.; Xie, Z.; Li, G.; Wang, X. Dual coordination between stereochemistry and cations endows polyethylene terephthalate fabrics with diversiform antimicrobial abilities for attack and defense. ACS Appl. Mater. Interfaces 2023, 15, 9926–9939. [Google Scholar] [CrossRef] [PubMed]
- Kumar, S.; Dutta, J.; Dutta, P.K. Preparation and characterization of N-heterocyclic chitosan derivative based gels for biomedical applications. Int. J. Biol. Macromol. 2009, 45, 330–337. [Google Scholar] [CrossRef]
- Wang, J.; Sui, M.; Ma, Z.; Li, H.; Yuan, B. Antibacterial performance of polymer quaternary ammonium salt–capped silver nanoparticles on Bacillus subtilis in water. RSC Adv. 2019, 9, 25667–25676. [Google Scholar] [CrossRef] [PubMed]
- Zhou, Z.; Zhou, S.; Zhang, X.; Zeng, S.; Xu, Y.; Nie, W.; Zhou, Y.; Xu, T.; Chen, P. Quaternary ammonium salts: Insights into synthesis and new directions in antibacterial applications. Bioconjug. Chem. 2023, 34, 302–325. [Google Scholar] [CrossRef] [PubMed]
- Liu, L.; Shi, H.; Yu, H.; Yan, S.; Luan, S. The recent advances in surface antibacterial strategies for biomedical catheters. Biomater. Sci. 2020, 8, 4095–4108. [Google Scholar] [CrossRef] [PubMed]
- Wang, Y.; Yuan, Q.; Li, M.; Tang, Y. Cationic conjugated microporous polymers coating for dual-modal antimicrobial inactivation with self-sterilization and reusability functions. Adv. Funct. Mater. 2023, 33, 2213440. [Google Scholar] [CrossRef]
- Chandrasekaran, M.; Kim, K.D.; Chun, S.C. Antibacterial activity of chitosan nanoparticles: A review. Processes 2020, 8, 1173. [Google Scholar] [CrossRef]
- Mueller, J.H.; Hinton, J. A protein-free medium for primary isolation of the Gonococcus and Me-ningococcus. Proc. Soc. Exp. Biol. Med. 1941, 48, 330–333. [Google Scholar] [CrossRef]
- CLSI. Performance Standards for Antimicrobial Susceptibility Testing, 25th ed.; Clinical and Laboratory Standards Institute (CLSI): Wayne, PA, USA, 2015; pp. 158–176. [Google Scholar]

Disclaimer/Publisher’s Note: The statements, opinions and data contained in all publications are solely those of the individual author(s) and contributor(s) and not of MDPI and/or the editor(s). MDPI and/or the editor(s) disclaim responsibility for any injury to people or property resulting from any ideas, methods, instructions or products referred to in the content. |
© 2024 by the authors. Licensee MDPI, Basel, Switzerland. This article is an open access article distributed under the terms and conditions of the Creative Commons Attribution (CC BY) license (https://creativecommons.org/licenses/by/4.0/).
Share and Cite
Xie, Z.; Zheng, Z.; Chen, C.; Li, G.; Wang, X. Borneol-Modified Chitosan Coating with Antibacterial Properties via Layer-by-Layer Strategy. Coatings 2024, 14, 381. https://doi.org/10.3390/coatings14040381
Xie Z, Zheng Z, Chen C, Li G, Wang X. Borneol-Modified Chitosan Coating with Antibacterial Properties via Layer-by-Layer Strategy. Coatings. 2024; 14(4):381. https://doi.org/10.3390/coatings14040381
Chicago/Turabian StyleXie, Zixu, Zhiran Zheng, Chen Chen, Guofeng Li, and Xing Wang. 2024. "Borneol-Modified Chitosan Coating with Antibacterial Properties via Layer-by-Layer Strategy" Coatings 14, no. 4: 381. https://doi.org/10.3390/coatings14040381
APA StyleXie, Z., Zheng, Z., Chen, C., Li, G., & Wang, X. (2024). Borneol-Modified Chitosan Coating with Antibacterial Properties via Layer-by-Layer Strategy. Coatings, 14(4), 381. https://doi.org/10.3390/coatings14040381






